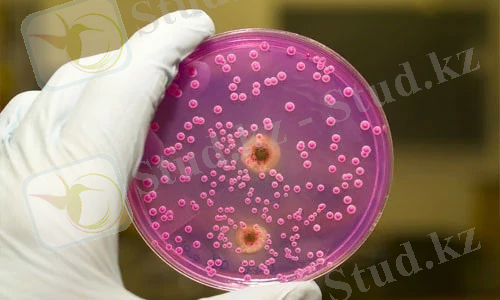
Астанада сальмонеллез індетін жұқтырғандар саны көбейді

Құс етіндегі сальмонеллез: сипаттама, диагностикалық әдістер және ветеринариялық санитариялық сараптау


Жоспары:
І. Кіріспе3 ІІ. Негізгі бөлім 2. 1 Сальмонеллезге жалпы сипаттама 4 2. 2 Сальмонелла тобына жататын микробтарды анықтау 4-8 2. 3 Сальмонеллезбен ауырған құс ұшасын ветсан сараптау және бағалау8-9 ІІІ. Қорытынды11 ІҮ. Пайдаланылған әдебиеттер тізімі12
І. Кіріспе
Адамда мал өнімдерінен жұғатын улы індеттер және бактерияның уларме улану көптеп кездеседі. Бұл ауруларың ішінде ет және басқа тағамдармен улануда сальмонелла бактерияларының маңызы зор. Сальмонеллез бактериялары сыртқы ортада өте кең тараған. Олар тіпті сау адамның, жануарлардың ішек-қарынында да кездеседі. Сонымен қатар, тағамдарды дайындауда санитариялық ережелер толық сақталмаған және сақтау ережелері бұзылған жағдайда бактериялар тез көбейіп, адамға қауіпті болуы мүмкін. Сонымен қатар адамның тамақтан улануына қатысатын көптеген бір - біріне өте ұқсас бактериялар бар. Олардың көбісі бір тұқымдас. Сондықтан да құс етін және ет өнімдерін бактериялық тексеруден өткізгенде бактерияның түрін анықтау едәуір қиындық туғызады. Улы індетті қоздырушыларға сальмонелла, ішек таяқшасы, протей және басқалар жатады. Бүлардың ішіндегі ең қауіптісі сальмонелла болып табылады. Сальмонелла туыстығына (род) жататын көптеген бактериялардың морфологиялық және культуралдық қасиеттері бойынша бір-бірінен өзгешеліктері жоқ. Сонымен қатар олардың Escherichia және Shigella туыстығымен көп ұқсастығы бар.
ІІ. Негізгі бөлім 2. 1 Сальмонеллезге жалпы сипаттама Сальмонеллез - Salmonella, бактериялардың жұқтыру нәтижесінде туындайтын, ас қорыту жүйесінің жұқпалы ауру. Salmonella - жылжымалы, факультативті анаэробты, таяқша тәрізді микроорганизмдер . Ортада салыстырмалы түрде тұрақты . Етте жарты жыл, бір жыл немесе одан да көп, құс ұшасы алты айға дейін, топырақтағы 5 ай дейін қалады жұмыртқа ұнтағында жылы температурада 3-9 ай және жұмыртқа қабығында 17-24 күн болады . Salmonella 70 ° C температурада 5-10 минуттан кейін өледі ет үлкен қалыңдығы бар болса, біраз уақыт бойы қайнағанға төзеді. Пісіру жұмыртқаны 4 минут кейін өледі. Микроағзаларға тұздалған ет өте төзімді болып табылады және ысталған, және мұздату өмірін ұзақтығын арттырады. Антибиотик және зарарсыздандыру құралдарына қарсылық жоғары дәрежесі бар Salmonella штаммдары - Қазіргі уақытта резидент (аурухана басқаша) бөлінген. Резервуар және Salmonella көзі мал, құс, кейбір жабайы жануарлар. Жануарлардың, ауру симптоматикалық және симптомсыз де орын алуы мүмкін. Құстар қоршаған ортаға және азық-түлік ластауы мүмкін. Salmonella жіктелуі және Salmonella бактериялары бөлінеді жұқпалы процесінің көлемі асқазан-ішек, жалпылау сальмонеллез екі нұсқасы бар tifopodobnaya және септикалық пайда болуы мүмкін. Бактериялар бөлетін өткір, созылмалы және транзиттік сипаты болуы мүмкін. Сальмонеллез белгілері. Сальмонеллез үшін инкубациялық кезең екі күн бірнеше сағаттан созылады. Аурудың клиникалық көріністерінің нұсқасына байланысты. Ең көп таралған нысаны сальмонеллез gastroenteritichesky нұсқасы. Ол жалпы интоксикация және су-тұз алмасуының бұзылуынан сипатталады. [2]
2. 2 Сальмонелла тобына жататын микробтарды анықтау Сальмонелла қоздырушысы Enterobacteriaceae тұқымдастарының ішінде Salmonella туыстығына жатады. Қазіргі кезде сальмонелланың 2000-ға жуық серотиптері бар. Олар бір-бірінен антиген құрылымы және ферменттік белсенділігі бойынша ажыратылады. Сальмонелланы анықтаудың негізі оның іріктеу (Элективті) қоректік ортасында өсу ерекшеліктеріне және серологиялық, ферментативтік қасиеттеріне көңіл аударады. Сальмонелла анықтау біртіндеп жүргізілетін 4 кезеңнен тұрады деп қарауға болады; бірінші себу, байыту, байыту ортасына қайта себу және анықтау. Өсу және морфологиялық ерекшеліктері бойынша сальмонелла Грамм әдісімен боялмайды, барлық анилин бояуларымен жақсы боялады, спор және капсула түзілмейді, қозғалу қабілеті жоғары (кейбір серотиптерінен басқа), кәдімгі қоздырушысы аэроб немесе факультативті анаэроб. Бактериологиялық шыныаяқтағы пептонда диаметрі 1-3мм-дей болатын ақшыл сұр түсті шоғыр түзейді. Олар S, R кейде аралықтағы O (SR) пішініндегі шоғыр түрінде кездеседі. S пішінді шоғыр кішкене, жылтыр дөңгелекше шеті тегіс, үсті күмюез тәріздес болса, R пішініндегі шоғырдың айналасы бұжырлы, үсті жалпақ, түсі күңгірт болып келеді. R пішініндегі себінді S пішініндегі микробтардан, сонымен қатар биохимиялық және серологиялық қасиеттерімен де өзгешеленеді. Жалпы алғанда сальмонелла қоздырушыларының биохимиялық ерекшеліктері төмендегіше сипатталады. Олардың ферменті мочевинаны, сүт қантын, қантты (сахароза), адонитті және салицинды, көпшілік түрі желатинді ыдыратпайды және индол ацетилметилкарбинол түземейді. Сальмонеллалар ферменті глюкозаны, галактозаны, маннозаны, фруктозаны, арабинозаны, рамнозаны, ксилозаны, маннитті, мальтозаны, глицеринді, дульцитті және сорбитті газ және қышқыл түзей ыдыратады. Сонымен қатар бұл бактериялар нитратты нитритке айналдырады, күкіртті сутек түзейді. Сальмонелла бактерияларының антигеннің құрылысы өте күрделі. Оларда екі негізгі антигенді кешен болады: денелік жоғарғы температурада тұрақты О-антиген және микроб жіпшесінің, температурады тұрақсыз Н-антигені. Соңғы антигеннің 1- және 2- фазасы бар. Сальмонелла жіктеудің негізінде оның антигеннің құрылымы алынған. Кауфман-Уайттың жіктеуі бойынша сальмонелланың тобы және серотипі ажыратылады. Осы Кауфман-Уайт үлгісі бойынша қазіргі кезде сальмонелланың 2000-ға тарта түрі бар. Материалды тексеру бінеше кезеңде жүргізіледі. 1-күн. Тексерілетін құс етін ЕПС, ЕПА ажыратушы қоректік орталарға (Эндо, Левинағ Плоскирев, висмут-сульфитті агар) және байыту орталарына (селинитті, Кауфман, Мюллер, Киллиани) себіледі.
1-сурет: Бактериологиялық шыныаяқ (ЕПА)
1-сурет: Бактериологиялық шыныаяқ (ЕПА)
Бактериологиялық шыныаяқты қоректік ортаға себуді тексерілетін үлгілерлің кішкене бөлігімен жүргізілетін дұрыс. Ол үшін еттің беті қызырылған қалақпен күйдіріледі де ортасынан зарарсыздандырылған қайшымен, қысқыштың көмегімен ішкене бөлігі кесіліп алынады. Ол шыныаяқтағы ортаның үстіне жағылады. Әр түрлі қоректік ортаға материалдың жаңа бөлшегін алған дұрыс. Ал ЕПС-на себу Пастер тамызғышының көмегімен жүргізіледі. Себілген қоректік орталар термостатқа 37С 18-20 сағатқа қойылады. Бактериологиялық ортаға себумен қатар, материалдан жұғынды алынып, Грамм әдісімен боялады. 2-күн. 18-24 сағаттан соң себінді тексеріліп, күдікті шоғырлар белгіленеді. Сұйық қоректік ортадан, қатты қоректік ортаға ауыстырып себеді. Күдікті шоғырларды бөлу үшін бактериологиялық шыныаяқтағы себінді көзбен немесе лупаның көмегімен мұқият тексеріледі. Эндо қоректік ортасында сльмонеллалар әлсіз көкшіл немесе түссіз шоғыр түрінде кездеседі. Плоскирев ортасында да түссіз және аздап қатқылдау, кейде күңгірт түрде болуы мүмкін. Левин ортасында сальмонеллалар мөлдір кейде көкшіл шоғыр түрінде өседі. Висмут-сульфитті агарда сальмонеллалардың басым көпшілігі жылтыр қара шоғыр күйінде өсіп және шоғыр өскен жердегі агарда қара түске енеді. Тек қана С тобындағы сальмонеллалар бұл ортада жылтыр, жасыл шоғыр түрінде байқалады. Висмут-сульфитті агардағы себінді 24-48 сағаттан соң тексеріледі. Себіндіден күдікті шоғырлар кездескен жағдайда олардан жағынды алынып, Грамм әдісімен боялады. Барлық күдікті шоғырлардан, жартылай сұйық (қоймалжың) немесе қалытқылы сұйық глюкоза, лактоза, сахароза, манниті бар Гисс орталарына (түсті қатар) және индол, күкіртті сутек түзеуін анықтау үшін ЕПС немесе 1%-ті пептонды суға себіледі. Бұл үшін ЕПС немесе пептонды су ЕПС немесе пептонды су құйылған пробирканың тығынына индолды және күкіртті сутекті анықтайтын Сальмонеллез қоздырушысының қозғалу қабілетін анықтау үшін қоймалжың ортаға (0, 2% агарлы) себіледі немесе Гисс орталықтарындағы өсу ерекшеліктері бойынша анықталады. Қозғалу қабілеті жоқ микробтар ортаның басқа жерлерінде де байқалады, бұл кезде орта күңгірттенеді. Сонымен қатар күдікті шоғырлардан монорецепторлы сарысулармен аглютинация реакциясы жүргізіледі. Серологиялық тексеру оң реакция берген жағдайда сальмонеллез туралы алғашқы қорытынды жасалады. 3-күн. Түрлі-түсті қатарға егілген микробтардың биохимиялық қасиеттері ажыратылады, Петри шыгыаяғындағы сұйық ортадан себілген шоғырлардың ерекшеліктері тексеріледі. Егер түрлі-түсті қатарда себілген микробтардың ферменттері лактоза мен сахарозаны ыдыратпаған болса, ал глюкоза ыдыраса, индол түземесе, мұндай бектериалар мен көп валентті О-сывороткасының В, С1, С2, Д1, Е1 топтарымен аглютинация еакциясы жүргізіледі. Аглютинация реакциясын жүргізу үшін майдан тазартылған төсеніш шыныға бір тамшы сарысу тамызып, оған бактериалдық ілгектің көмегімен 20 сағаттық агардағы себінді қосылады. Қосынды жақсылап араластырылады. О-агглютинация жылдам жүреді, бұл кезде сарысуда қатқыл түйіршіктер, үймелер пайда болады. Егер сальмонеллез қоздырушысының түрін анықтау қажет болса, көп валентті О сывароткасымен агглютинация берген микроб, Н-рецепторлы антигендермен қосымша агглютинация реакциясы жүргізіліп, Кауфман-Уайт үлгісі бойынша анықтайды. Бөлінген себіндіі морфолоиялық, биохимиялық және өсу ерекшеліктері бойынша сальмонеллез қоздырушысына сәйкес келсе және агглютинация реакциясы оң жағдайды көрсетсе, сальмонеллез дәлелденеді деп есептелінеді.
 2-сурет: Сальмонелла қоздырушысы
2-сурет: Сальмонелла қоздырушысы
Егер бірінші күнгі себіндіде сальмонелла қоздырушысына(1-сурет) күдікті шоғырлар кездеспесе, ал сұйық қоректік ортадан ажыратушы қатты ортаға себілген микробтардың күдікті шоғырлар пайда болса, онда осы шоғырлармен жоғарыда көрсетілгендей зерттеулер қайта жүргізіледі. Ал бұл екі жағдайда да күдікті шоғырлар пйда болмаса, сальмонеллез қоздырушысы жоқ деген қорытынды жасалады. 4-күн. Түрлі-түсті қатарға себілген бактериялар ферменттерінің қасиеттері тексеріліп, агглютинация реакциясы жүргізіледі. [3]
... жалғасы- Іс жүргізу
- Автоматтандыру, Техника
- Алғашқы әскери дайындық
- Астрономия
- Ауыл шаруашылығы
- Банк ісі
- Бизнесті бағалау
- Биология
- Бухгалтерлік іс
- Валеология
- Ветеринария
- География
- Геология, Геофизика, Геодезия
- Дін
- Ет, сүт, шарап өнімдері
- Жалпы тарих
- Жер кадастрі, Жылжымайтын мүлік
- Журналистика
- Информатика
- Кеден ісі
- Маркетинг
- Математика, Геометрия
- Медицина
- Мемлекеттік басқару
- Менеджмент
- Мұнай, Газ
- Мұрағат ісі
- Мәдениеттану
- ОБЖ (Основы безопасности жизнедеятельности)
- Педагогика
- Полиграфия
- Психология
- Салық
- Саясаттану
- Сақтандыру
- Сертификаттау, стандарттау
- Социология, Демография
- Спорт
- Статистика
- Тілтану, Филология
- Тарихи тұлғалар
- Тау-кен ісі
- Транспорт
- Туризм
- Физика
- Философия
- Халықаралық қатынастар
- Химия
- Экология, Қоршаған ортаны қорғау
- Экономика
- Экономикалық география
- Электротехника
- Қазақстан тарихы
- Қаржы
- Құрылыс
- Құқық, Криминалистика
- Әдебиет
- Өнер, музыка
- Өнеркәсіп, Өндіріс
Қазақ тілінде жазылған рефераттар, курстық жұмыстар, дипломдық жұмыстар бойынша біздің қор #1 болып табылады.



Ақпарат
Қосымша
Email: info@stud.kz